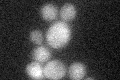
YJR136C
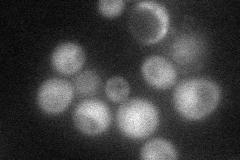
YJR136C
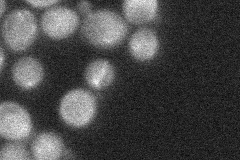
YJR136C
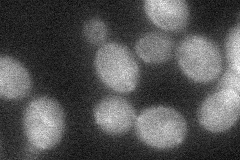
YJR136C
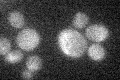
YJR136C

View description
Putative protein of unknown function; subunit of the ASTRA complex which is part of the chromatin remodeling machinery; similar to S. pombe Tti2p; may interact with Rsm23p; GFP-fusion protein localizes to the cytoplasm
Localization:
Intensity:
Fold change:
Significance:
-
C’ GFP library in SD
cytosol21.76 -
N' NOP1pr-GFP in SD
cytosol44.3929 -
N' TEF2pr-mCherry in SD

nucleus22.7103 -
N' NATIVEpr-GFP in SD
below threshold25.7927 -
N' TEF2pr-VC and Cyto-VN in SD
cytosol32.0025 -
C’ GFP library in SD+DTT

cytosol21.811No -
C’ GFP library in SD+H2O2

cytosol22.121.01No -
C’ GFP library in Starvation Media
cytosol18.040.82No -
C’ GFP library on the background of Pup2-DaMP

cytosol -
C’ GFP library on the background of CCT mutant

cytosol23.40951.07525No
